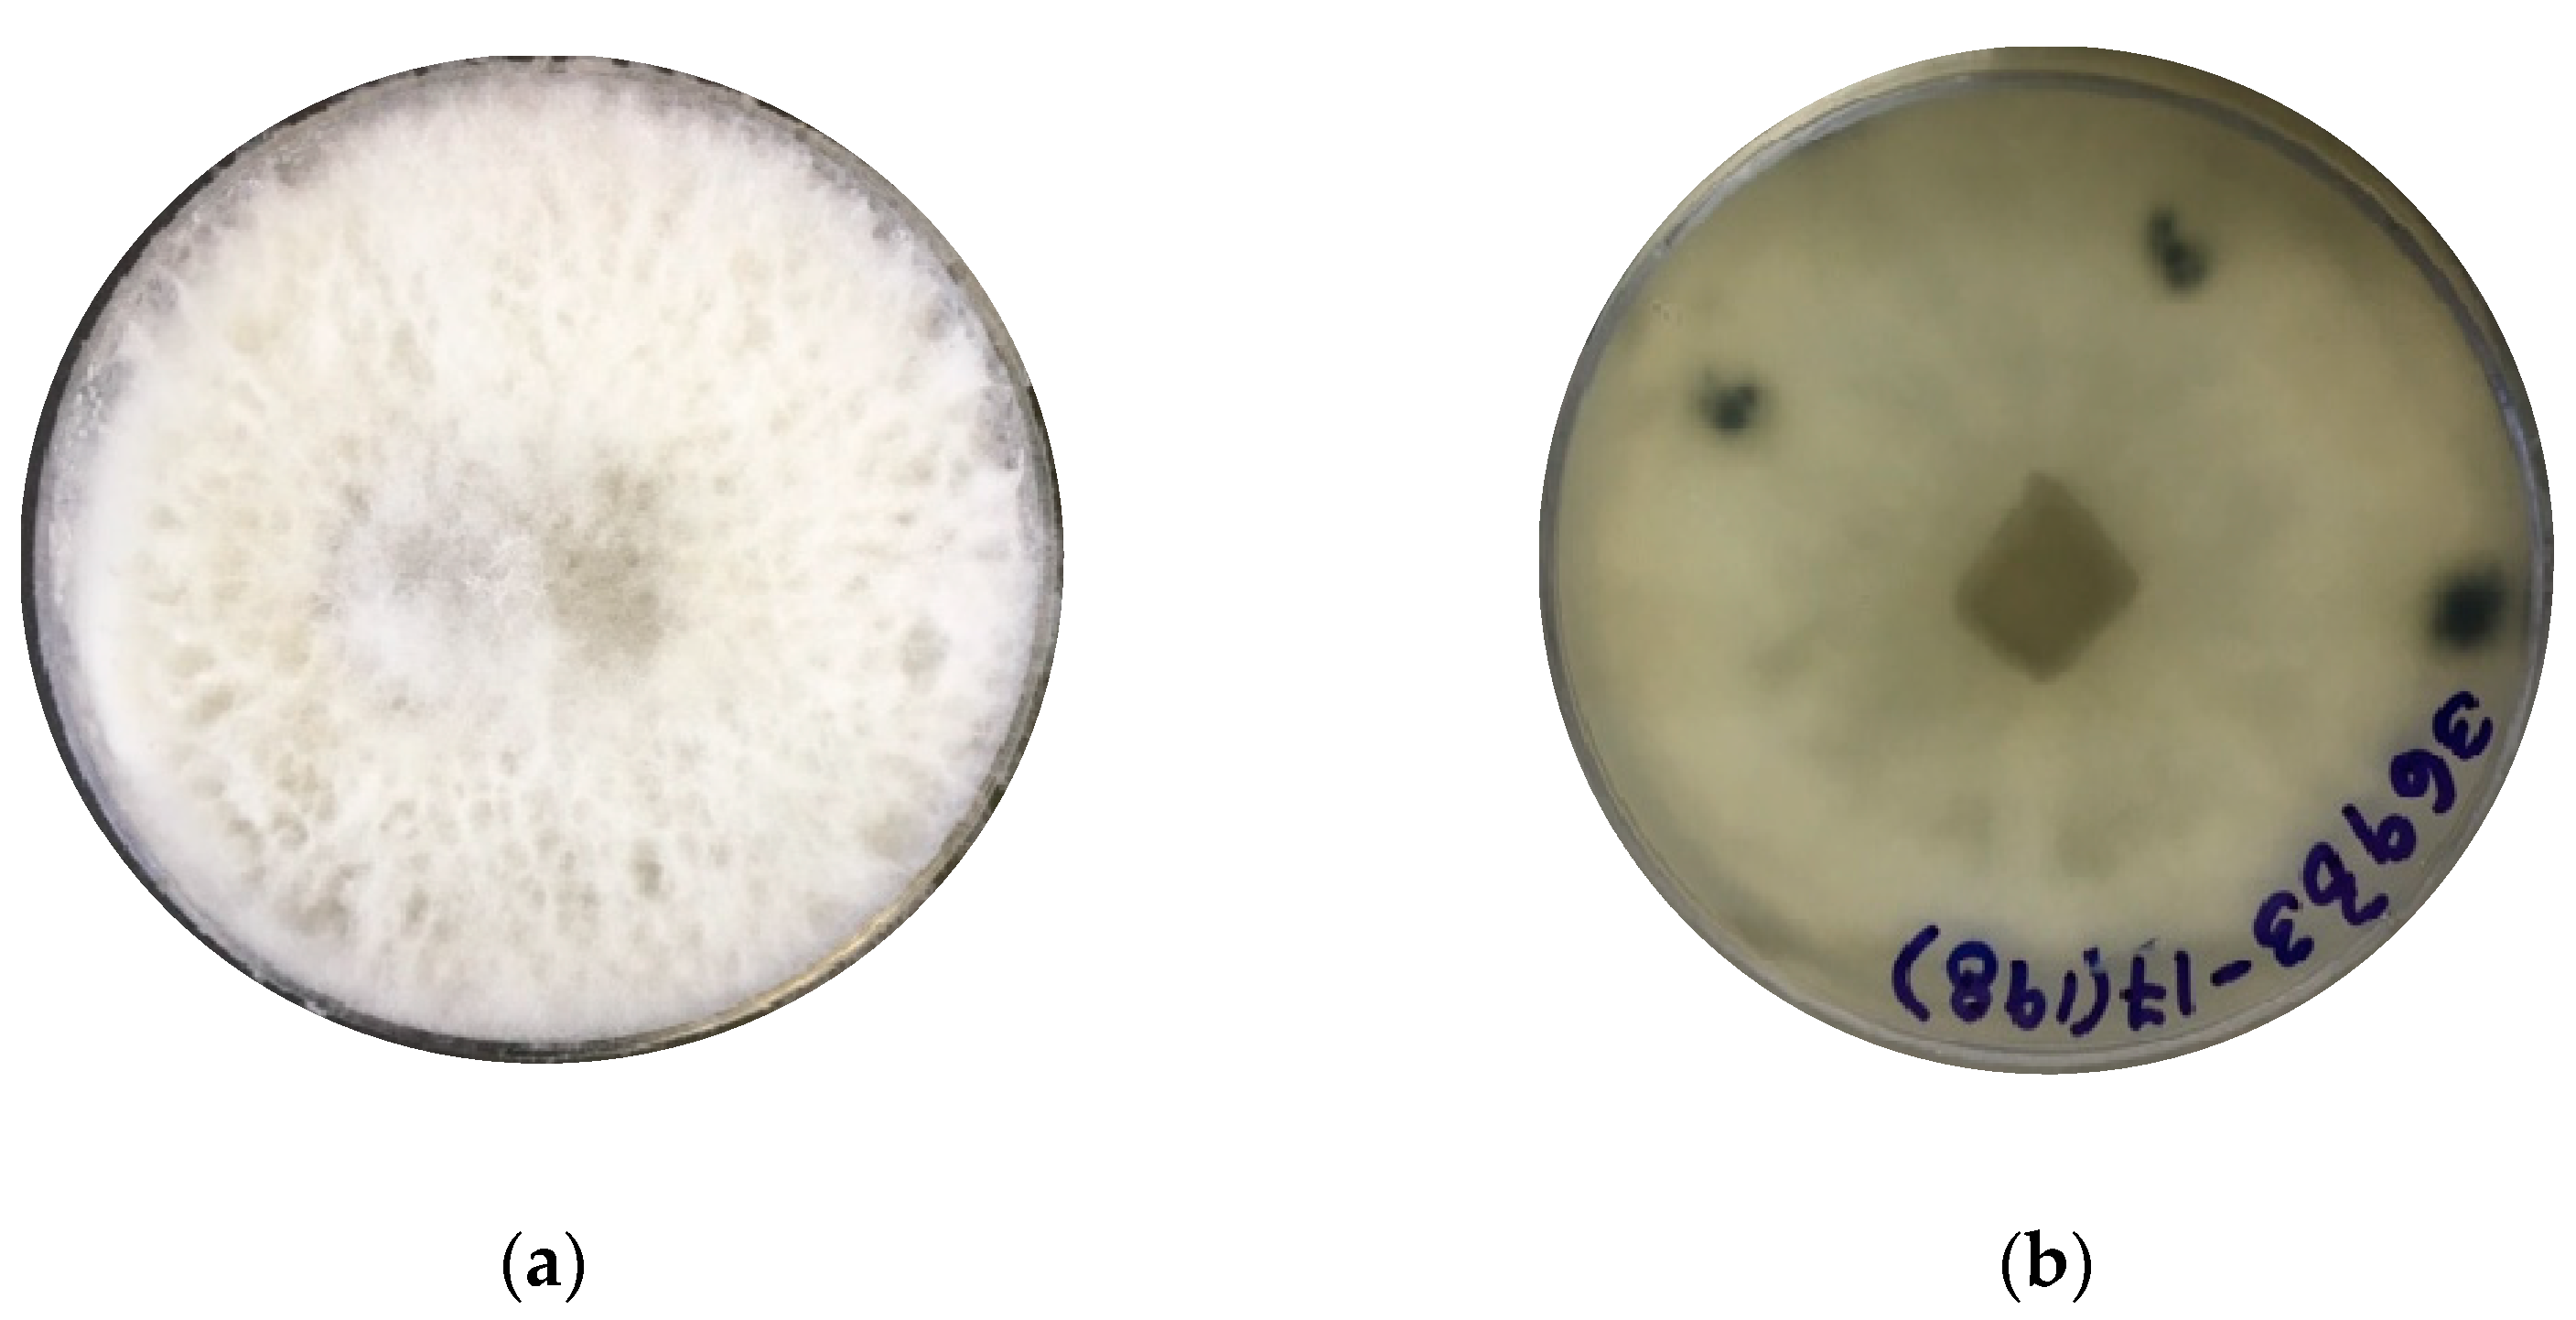

Identification of Secondary Metabolites from the Mangrove-Endophyte Lasiodiplodia iranensis F0619 by UPLC-ESI-MS/MS
Abstract
1. Introduction
2. Material and Methods
2.1. Chemicals and Reagents
2.2. Strain Isolation and Identification
- Active mycelium from three plugs was aseptically transferred to two Petri dishes (145 mm × 20 mm) of fresh MEA and incubated at 26 °C for 10 days. Subsequently, the mycelia were ground with liquid nitrogen until a fine powder was obtained, then was stored at −80 °C until further analysis. Genomic DNA (gDNA) was extracted from 125 mg of frozen biomass using the Quick-DNA Fungal/Bacterial Miniprep Kit (Zymo Research Corp., Irvine, CA, USA, Cat No. D6005) protocol according to the manufacturer’s instructions. The quality and concentration of gDNA were quantified using a NanodropTM Spectrophotometer (ThermoFisher Scientific, Waltham, MA, USA).
2.3. Initial Cultivation and Extraction
2.4. Fractionation of the Crude Extract and Analysis of Fractions by HPLC
2.5. Analysis of Fractions by LC-PDA-MS/MS
3. Results
3.1. Characterization and Identification of Biological Material
3.2. Extraction, Fractionation, and TLC and HPLC Profile of Fractions
3.3. Metabolites Identification by Liquid Chromatography-Tandem Mass Spectrometry
4. Discussion
4.1. Fungal Strain Identification
4.2. Structural Characterization of Metabolites
Supplementary Materials
Author Contributions
Funding
Institutional Review Board Statement
Informed Consent Statement
Data Availability Statement
Acknowledgments
Conflicts of Interest
References
- Byregowda, R.; Prasad, S.R.; Oelmüller, R.; Nataraja, K.N.; Kumar, M.K.P. Is Endophytic Colonization of Host Plants a Method of Alleviating Drought Stress? Conceptualizing the Hidden World of Endophytes. Int. J. Mol. Sci. 2022, 23, 9194. [Google Scholar] [CrossRef]
- Manganyi, M.C.; Ateba, C.N. Untapped Potentials of Endophytic Fungi: A Review of Novel Bioactive Compounds with Biological Applications. Microorganisms 2020, 8, 1934. [Google Scholar] [CrossRef] [PubMed]
- Torres-Mendoza, D.; Ortega, H.E.; Cubilla-Rios, L. Patents on Endophytic Fungi Related to Secondary Metabolites and Biotransformation Applications. J. Fungi 2020, 6, 58. [Google Scholar] [CrossRef]
- Ortega, H.E.; Torres-Mendoza, D.; Cubilla-Rios, L. Patents on Endophytic Fungi for Agriculture and Bio- and Phytoremediation Applications. Microorganisms 2020, 8, 1237. [Google Scholar] [CrossRef]
- Bogas, A.C.; Cruz, F.P.N.; Lacava, P.T.; Sousa, C.P. Endophytic Fungi: An Overview on Biotechnological and Agronomic Potential Fungos Endofíticos: Uma Visão Geral Sobre o Potencial Biotecnológico e Agronômico. Braz. J. Biol. 2022, 84, 1–9. [Google Scholar] [CrossRef]
- Demers, D.H.; Knestrick, M.A.; Fleeman, R.; Tawfik, R.; Azhari, A.; Souza, A.; Vesely, B.; Netherton, M.; Gupta, R.; Colon, B.L.; et al. Exploitation of Mangrove Endophytic Fungi for Infectious Disease Drug Discovery. Mar. Drugs 2018, 16, 376. [Google Scholar] [CrossRef]
- Ancheeva, E.; Daletos, G.; Proksch, P. Lead Compounds from Mangrove-Associated Microorganisms. Mar. Drugs 2018, 16, 319. [Google Scholar] [CrossRef] [PubMed]
- Cadamuro, R.D.; Maria, I.; Bastos, S.; Silva, I.T.; Cristiane, A.; Robl, D.; Sandjo, L.P.; Alves, S.; Lorenzo, J.M.; Rodr, D.; et al. Bioactive Compounds from Mangrove Endophytic Fungus and Their Uses for Microorganism Control. J. Fungi 2021, 7, 455. [Google Scholar] [CrossRef]
- Deshmukh, S.K.; Gupta, M.K.; Prakash, V.; Reddy, M.S. Mangrove-Associated Fungi: A Novel Source of Potential Anticancer Compounds. J. Fungi 2018, 4, 101. [Google Scholar] [CrossRef] [PubMed]
- Ortega, H.E.; Torres-Mendoza, D.; E, Z.C.; Cubilla-Rios, L. Structurally Uncommon Secondary Metabolites Derived from Endophytic Fungi. J. Fungi 2021, 7, 570. [Google Scholar] [CrossRef]
- Salvatore, M.M.; Alves, A.; Andolfi, A. Secondary Metabolites of Lasiodiplodia theobromae: Distribution, Chemical Diversity, Bioactivity, and Implications of Their Occurrence. Toxins 2020, 12, 29. [Google Scholar] [CrossRef] [PubMed]
- Philippini, R.R.; Martiniano, S.E.; Franco Marcelino, P.R.; Chandel, A.K.; dos Santos, J.C.; Da Silva, S.S. Production of β-Glucan Exopolysaccharide Lasiodiplodan by Lasiodiplodia theobromae CCT 3966 from Corn Bran Acid Hydrolysate. Appl. Microbiol. Biotechnol. 2021, 105, 2319–2332. [Google Scholar] [CrossRef]
- Félix, C.; Libório, S.; Nunes, M.; Félix, R.; Duarte, A.S.; Alves, A.; Esteves, A.C. Lasiodiplodia theobromae as a Producer of Biotechnologically Relevant Enzymes. Int. J. Mol. Sci. 2018, 19, 15. [Google Scholar] [CrossRef] [PubMed]
- Cabezas Gómez, O.; Barbosa Moreira, D.M.; Hortolan Luiz, J.H. Medicinal Potentialities and Pathogenic Profile of Lasiodiplodia Genus. World J. Microbiol. Biotechnol. 2021, 37, 190. [Google Scholar] [CrossRef]
- Kumar, S.; Pagar, A.D.; Ahmad, F.; Dwibedi, V.; Wani, A.; Bharatam, P.V.; Chhibber, M.; Saxena, S.; Pal Singh, I. Xanthine Oxidase Inhibitors from an Endophytic Fungus Lasiodiplodia pseudotheobromae. Bioorg Chem. 2019, 87, 851–856. [Google Scholar] [CrossRef]
- Pellissier, L.; Koval, A.; Marcourt, L.; Ferreira Queiroz, E.; Lecoultre, N.; Leoni, S.; Quiros-Guerrero, L.M.; Barthélémy, M.; Duivelshof, B.L.; Guillarme, D.; et al. Isolation and Identification of Isocoumarin Derivatives with Specific Inhibitory Activity Against Wnt Pathway and Metabolome Characterization of Lasiodiplodia venezuelensis. Front. Chem. 2021, 9, 664489. [Google Scholar] [CrossRef]
- Pellissier, L.; Leoni, S.; Marcourt, L.; Queiroz, E.F.; Lecoultre, N.; Quiros-Guerrero, L.M.; Barthélémy, M.; Eparvier, V.; Chave, J.; Stien, D.; et al. Characterization of Pseudomonas aeruginosa Quorum Sensing Inhibitors from the Endophyte Lasiodiplodia venezuelensis and Evaluation of Their Antivirulence Effects by Metabolomics. Microorganisms 2021, 9, 1807. [Google Scholar] [CrossRef]
- Li, J.; Xue, Y.; Yuan, J.; Lu, Y.; Zhu, X.; Lin, Y.; Liu, L. Lasiodiplodins from Mangrove Endophytic Fungus Lasiodiplodia sp. 318#. Nat. Prod. Res. 2016, 30, 755–760. [Google Scholar] [CrossRef] [PubMed]
- Huang, J.; Xu, J.; Wang, Z.; Khan, D.; Niaz, S.I.; Zhu, Y.; Lin, Y.; Li, J.; Liu, L. New Lasiodiplodins from Mangrove Endophytic Fungus Lasiodiplodia sp. 318#. Nat. Prod. Res. 2017, 31, 326–332. [Google Scholar] [CrossRef]
- Chen, S.; Liu, Z.; Liu, H.; Long, Y.; Chen, D.; Lu, Y.; She, Z. Lasiodiplactone A, a Novel Lactone from the Mangrove Endophytic Fungus Lasiodiplodia theobromae ZJ-HQ1. Org. Biomol. Chem. 2017, 15, 6338–6341. [Google Scholar] [CrossRef]
- Sato, S.; Sofian, F.F.; Suehiro, W.; Harneti, D.; Maharani, R.; Supratman, U.; Abdullah, F.F.; Salam, S.; Koseki, T.; Shiono, Y. β-Resorcylic Acid Derivatives, with Their Phytotoxic Activities, from the Endophytic Fungus Lasiodiplodia theobromae in the Mangrove Plant Xylocarpus granatum. Chem. Biodivers. 2021, 18, e2000928. [Google Scholar] [CrossRef]
- Chen, S.; Chen, D.; Cai, R.; Cui, H.; Long, Y.; Lu, Y.; Li, C.; She, Z. Cytotoxic and Antibacterial Preussomerins from the Mangrove Endophytic Fungus Lasiodiplodia theobromae ZJ-HQ1. J. Nat. Prod. 2016, 79, 2397–2402. [Google Scholar] [CrossRef]
- Matsui, R.; Amano, N.; Takahashi, K.; Taguchi, Y.; Saburi, W.; Mori, H.; Kondo, N.; Matsuda, K.; Matsuura, H. Elucidation of the Biosynthetic Pathway of Cis-Jasmone in Lasiodiplodia theobromae. Sci. Rep. 2017, 7, 6688. [Google Scholar] [CrossRef]
- Eng, F.; Marin, J.E.; Zienkiewicz, K.; Gutiérrez-Rojas, M.; Favela-Torres, E.; Feussner, I. Jasmonic Acid Biosynthesis by Fungi: Derivatives, First Evidence on Biochemical Pathways and Culture Conditions for Production. PeerJ 2021, 9, e10873. [Google Scholar] [CrossRef] [PubMed]
- Eng, F.; Haroth, S.; Feussner, K.; Meldau, D.; Rekhter, D.; Ischebeck, T.; Brodhun, F.; Feussner, I. Optimized Jasmonic Acid Production by Lasiodiplodia theobromae Reveals Formation of Valuable Plant Secondary Metabolites. PLoS ONE 2016, 11, e0167627. [Google Scholar] [CrossRef]
- Andolfi, A.; Maddau, L.; Cimmino, A.; Linaldeddu, B.T.; Basso, S.; Deidda, A.; Serra, S.; Evidente, A. Lasiojasmonates A-C, Three Jasmonic Acid Esters Produced by Lasiodiplodia sp., a Grapevine Pathogen. Phytochemistry 2014, 103, 145–153. [Google Scholar] [CrossRef] [PubMed]
- Shen, Z.; Zheng, P.; Li, R.; Sun, X.; Chen, P.; Wu, D. High Production of Jasmonic Acid by Lasiodiplodia iranensis Using Solid-State Fermentation: Optimization and Understanding. Biotechnol. J. 2022, 17, 2100550. [Google Scholar] [CrossRef] [PubMed]
- Shyaula, S.L.; Singh, Y.; Rawat, P.; Kanojiya, S. Comprehensive Characterization of Dactylorhin and Loroglossin in Dactylorhiza hatagirea, D. DON Using Ultra-Performance Liquid Chromatography-Mass Spectrometry. Int. J. Mass Spectrom. 2023, 490, 117069. [Google Scholar] [CrossRef]
- Liu, Z.Y.; Yu, C.H.; Wan, L.; Sun, Z.L. Fragmentation Study of Five Trichothecenes Using Electrospray Hybrid Ion Trap/Time-of-Flight Mass Spectrometry with Accurate Mass Measurements. Int. J. Mass Spectrom. 2012, 309, 133–140. [Google Scholar] [CrossRef]
- Lijina, P.; Gnanesh Kumar, B.S. Differentiating Planteose and Raffinose Using Negative Ion Mode Mass Spectrometry. Int. J. Mass Spectrom. 2023, 487, 117027. [Google Scholar] [CrossRef]
- Molinar, E.; Rios, N.; Spadafora, C.; Elizabeth Arnold, A.; Coley, P.D.; Kursar, T.A.; Gerwick, W.H.; Cubilla-Rios, L. Coibanoles, a New Class of Meroterpenoids Produced by Pycnoporus sanguineus. Tetrahedron Lett. 2012, 53, 919–922. [Google Scholar] [CrossRef] [PubMed]
- Humber, R.A. Fungi: Preservation of Cultures. In Manual of Techniques in Insect Pathology; Lacey, L.A., Ed.; Academic Press: Cambridge, MA, USA, 1997; pp. 269–279. ISBN 9780124325555. [Google Scholar]
- Harris, J.L. Letter to the Editor Safe, Low-Distortion Tape Touch Method for Fungal Slide Mounts. J. Clin. Microbiol. 2000, 38, 4683–4684. [Google Scholar] [CrossRef] [PubMed]
- Raja, H.A.; Miller, A.N.; Pearce, C.J.; Oberlies, N.H. Fungal Identification Using Molecular Tools: A Primer for the Natural Products Research Community. J. Nat. Prod. 2017, 80, 756–770. [Google Scholar] [CrossRef]
- White, T.J.; Bruns, T.; Lee, S.; Taylor, J. Amplification and direct sequencing of fungal ribosomal RNA genes for phylogenetics. In PCR Protocols; Elsevier: Amsterdam, The Netherlands, 1990; pp. 315–322. [Google Scholar]
- Hall, T.A. BioEdit: A user_friendly biological sequence Alignment Editor and Analysis Program for Windows 95/98 NT. Nucleic Acids Symp. Ser. 1999, 41, 95–98. [Google Scholar]
- Hall, T.A. BioEdit: An Important Software for Molecular Biology. GERF Bull. Biosci. 1991, 2, 60–61. [Google Scholar]
- Altschup, S.F.; Gish, W.; Miller, W.; Myers, E.W.; Lipman, D.J. Basic Local Alignment Search Tool. J. Mol. Biol. 1990, 215, 403–410. [Google Scholar] [CrossRef]
- Abdollahzadeh, J.; Javadi, A.; Goltapeh, E.M.; Zare, R.; Phillips, A.J.L. Phylogeny and Morphology of Four New Species of Lasiodiplodia from Iran. Persoonia Mol. Phylogeny Evol. Fungi 2010, 25, 1–10. [Google Scholar] [CrossRef]
- Rodríguez-Gálvez, E.; Guerrero, P.; Barradas, C.; Crous, P.W.; Alves, A. Phylogeny and Pathogenicity of Lasiodiplodia Species Associated with Dieback of Mango in Peru. Fungal Biol. 2017, 121, 452–465. [Google Scholar] [CrossRef]
- Wang, Y.; Lin, S.; Zhao, L.; Sun, X.; He, W.; Zhang, Y.; Dai, Y.-C. Lasiodiplodia spp. Associated with Aquilaria crassna in Laos. Mycol. Prog. 2019, 18, 683–701. [Google Scholar] [CrossRef]
- Tamura, K.; Stecher, G.; Kumar, S. MEGA11: Molecular Evolutionary Genetics Analysis Version 11. Mol. Biol. Evol. 2021, 38, 3022–3027. [Google Scholar] [CrossRef]
- Hasegawa, M.; Kishino, H.; Yano, T.A. Dating of the Human-Ape Splitting by a Molecular Clock of Mitochondrial DNA. J. Mol. Evol. 1985, 22, 160–174. [Google Scholar] [CrossRef]
- Martínez-Luis, S.; Ballesteros, J.; Gutiérrez, M. Antibacterial Constituents from the Octocoral-Associated Bacterium Pseudoalteromonas sp. Rev. Latinoamer. Quím 2011, 39, 75–83. [Google Scholar]
- Castillo, G.; Torrecillas, A.; Nogueiras, C.; Michelena, G.; Sánchez-Bravo, J.; Acosta, M. Simultaneous Quantification of Phytohormones in Fermentation Extracts of Botryodiplodia theobromae by Liquid Chromatography-Electrospray Tandem Mass Spectrometry. World J. Microbiol. Biotechnol. 2014, 30, 1937–1946. [Google Scholar] [CrossRef] [PubMed]
- El-Ganainy, S.M.; Ismail, A.M.; Iqbal, Z.; Elshewy, E.S.; Alhudaib, K.A.; Almaghasla, M.I.; Magistà, D. Diversity among Lasiodiplodia Species Causing Dieback, Root Rot and Leaf Spot on Fruit Trees in Egypt, and a Description of Lasiodiplodia newvalleyensis sp. nov. J. Fungi 2022, 8, 1203. [Google Scholar] [CrossRef]
- Reid, G.E.; Simpson, R.J.; O’Hair, R.A.J. A Mass Spectrometric and Ab Initio Study of the Pathways for Dehydration of Simple Glycine and Cysteine-Containing Peptide [M+H]+ Ions. J. Am. Soc. Mass. Spectrom. 1998, 9, 945–956. [Google Scholar] [CrossRef]
- Beynon, J.G.; Caprioli, R.M.; Shannon, T.W. The Structure of the Product Ion of a ‘McLafferty’ Rearrangement. Org. Mass. Spectrom. 1971, 5, 967–975. [Google Scholar] [CrossRef]
- Petersson, G. A McLafferty-type Rearrangement of a Trimethylsilyl Group in Silylated Hydroxy Carbonyl Compounds. Org. Mass. Spectrom. 1972, 6, 577–592. [Google Scholar] [CrossRef]
- Demarque, D.P.; Crotti, A.E.M.; Vessecchi, R.; Lopes, J.L.C.; Lopes, N.P. Fragmentation Reactions Using Electrospray Ionization Mass Spectrometry: An Important Tool for the Structural Elucidation and Characterization of Synthetic and Natural Products. Nat. Prod. Rep. 2016, 33, 432–455. [Google Scholar] [CrossRef]
- Gross, M.L. Charge-Remote Fragmentations: Method, Mechanism and Applications. Int. J. Mass Spectrom. Ion. Process 1992, 118–119, 137–165. [Google Scholar] [CrossRef]
- Furtado, N.A.J.C.; Vessecchi, R.; Tomaz, J.C.; Galembeck, S.E.; Bastos, J.K.; Lopes, N.P.; Crotti, A.E.M. Fragmentation of Diketopiperazines from Aspergillus fumigatus by Electrospray Ionization Tandem Mass Spectrometry (ESI-MS/MS). J. Mass Spectrom. 2007, 42, 1279–1286. [Google Scholar] [CrossRef]
- Oh, H.B.; Moon, B. Radical-Driven Peptide Backbone Dissociation Tandem Mass Spectrometry. Mass Spectrom. Rev. 2015, 34, 116–132. [Google Scholar] [CrossRef] [PubMed]
- Kokuev, A.O.; Sukhorukov, A.Y. Michael Addition of P-Nucleophiles to Azoalkenes Provides Simple Access to Phosphine Oxides Bearing an Alkylhydrazone Moiety. Front. Chem. 2023, 11, 1–9. [Google Scholar] [CrossRef] [PubMed]
- Vessecchi, R.; Julião Zocolo, G.; Rubio Gouvea, D.; Hübner, F.; Cramer, B.; Rodrigues De Marchi, M.R.; Humpf, H.U.; Lopes, N.P. Re-Examination of the Anion Derivatives of Isoflavones by Radical Fragmentation in Negative Electrospray Ionization Tandem Mass Spectrometry: Experimental and Computational Studies. Rapid Commun. Mass. Spectrom. 2011, 25, 2020–2026. [Google Scholar] [CrossRef]
- Ueda, M.; Kaji, T.; Kozaki, W. Recent Advances in Plant Chemical Biology of Jasmonates. Int. J. Mol. Sci. 2020, 21, 1124. [Google Scholar] [CrossRef] [PubMed]
- Li, Z.G.; Chen, K.X.; Xie, H.Y.; Gao, J.R. Quantitative Structure-Property Relationship Studies on Amino Acid Conjugates of Jasmonic Acid as Defense Signaling Molecules. J. Integr. Plant Biol. 2009, 51, 581–592. [Google Scholar] [CrossRef]

| Compound | Retention Time in Minutes (tR) | UV (nm) | Molecular Weight (g/mol) | [M + H]+ (m/z) | MS/MS Fragments Ions | Reference |
|---|---|---|---|---|---|---|
| 1 | 1.60–1.73 | 195, 233 | 208.26 | 209.1 | 191.1, 163.3, 149.3, 131.1, 121.1, 107.1, 71.0 | [11] |
| 2 | 3.55–3.95 | 227 | 208.25 | 209.3 | 191.2, 181.3, 167.3, 153.2, 149.0, 131.1, 121.0, 107.0, 93.1 | [11] |
| 3 | 4.30–4.50 | 205 | 210.27 | 211.2 | 194.1, 183.2, 166.3, 137.8, 114.3, 98.0, 86.3, 69.9 | [11,44] |
| 4 | 5.36–5.74 | 208, 235, 275 | 311.37 | 312.2 | 294, 266, 248, 198, 181, 125, 86 | [11,24,45] |
| 5 | 5.84–5.98 | 243 | 264.32 | 265.2 | 248.2, 221.2, 205.1, 180.1 | [11] |
Disclaimer/Publisher’s Note: The statements, opinions and data contained in all publications are solely those of the individual author(s) and contributor(s) and not of MDPI and/or the editor(s). MDPI and/or the editor(s) disclaim responsibility for any injury to people or property resulting from any ideas, methods, instructions or products referred to in the content. |
© 2023 by the authors. Licensee MDPI, Basel, Switzerland. This article is an open access article distributed under the terms and conditions of the Creative Commons Attribution (CC BY) license (https://creativecommons.org/licenses/by/4.0/).
Share and Cite
Delgado Gómez, L.M.; Torres-Mendoza, D.; Hernández-Torres, K.; Ortega, H.E.; Cubilla-Rios, L. Identification of Secondary Metabolites from the Mangrove-Endophyte Lasiodiplodia iranensis F0619 by UPLC-ESI-MS/MS. Metabolites 2023, 13, 912. https://doi.org/10.3390/metabo13080912
Delgado Gómez LM, Torres-Mendoza D, Hernández-Torres K, Ortega HE, Cubilla-Rios L. Identification of Secondary Metabolites from the Mangrove-Endophyte Lasiodiplodia iranensis F0619 by UPLC-ESI-MS/MS. Metabolites. 2023; 13(8):912. https://doi.org/10.3390/metabo13080912
Chicago/Turabian StyleDelgado Gómez, Lizbeth M., Daniel Torres-Mendoza, Kathleen Hernández-Torres, Humberto E. Ortega, and Luis Cubilla-Rios. 2023. "Identification of Secondary Metabolites from the Mangrove-Endophyte Lasiodiplodia iranensis F0619 by UPLC-ESI-MS/MS" Metabolites 13, no. 8: 912. https://doi.org/10.3390/metabo13080912
APA StyleDelgado Gómez, L. M., Torres-Mendoza, D., Hernández-Torres, K., Ortega, H. E., & Cubilla-Rios, L. (2023). Identification of Secondary Metabolites from the Mangrove-Endophyte Lasiodiplodia iranensis F0619 by UPLC-ESI-MS/MS. Metabolites, 13(8), 912. https://doi.org/10.3390/metabo13080912

